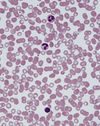

1
Q

A

2
Q

A
ileum
3
Q

A
sacrum
4
Q

A
pubis
5
Q

A
ischium
6
Q

A
pelvis, hip bone
7
Q

A
scapula
8
Q

A
humerus
9
Q

A
radius
10
Q

A
ulna
11
Q

A
carpus
12
Q

A
metacarpus
13
Q

A
phalanges
14
Q

A
tarsus
14
Q

A
metatarsus
15
Q

A
phalanges
16
Q

A
femur
17
Q

A
patella
18
Q

A
tibia
19
Q

A
fibula
20
Q

A
skull
21
Q

A
mandible
22
Q

A
cervical vertebrae
23
Q

A
clavicle
24

sternum
25

ribs
26

thoracic vertebrae
27

lumbar vertebrae
28

coccyx, tailbone
28

calcaneus
29
what part of the sternum is this

Manubrium
30
what part of the sternum is this?

Body
31
what part of the sternum is this

Xiphoid process
32
what is the name of this joint

sternoclavicle
33
what's the name of the joint

sternocostal
34
longitudinal or cross section
which muscle is this?

longitudinal
skeletal
35
longitudinal or cross section?
is the nuclei central or periphery?
locate the different connective tissues

cross section and periphery
endomysium surrounds one myofibril
perimysium (M) surrounds one bunde/fascicle

36
longitudinal or cross section?
what muscle?
is the nuclei central or periphery?

longitudinal
skeletal
periphery
37
longitudinal or cross section?
what muscle?

longitudinal
smooth
38
longitudinal or cross section?
what muscle?

longitudinal
cardiac
39
what type of connective tissue

loose irregular
you can see fibroblast nucleus, and collage and elastin fibres surrounding the fibroblasts
40
what type of connective tissue?

dense irregular
41
what type of connective tissue?

dense regular
42
what type of connective tissue?
specialised
RBC
43
what type of connective tissue?

adipose
44
what type of connective tissue?

cartilage
45
what type of connective tissue?

Bone
46
locate the foramen magnum and the conus medullaris


47
locate the conus medullaris


48
a nerve plexus is:
different nerve branches from different regions of CNS fusing together
49
a reflex is a ______, ________ sequence of actions triggered in response to a ________
where does it occur, and what does it bypass
fast, involuntary sequence of actions triggered in response to a stimuli
spinal level, bypassing the brain for quicker response
50
above spinal cord, its continous with the _______ _______ (part of brainstem), and below it ends in a tapering extremity called ______ _______
medulla oblongata
conus medullaris
51
adipose connective tissue does what (2)
1. stores energy
2. insulates
52
adipose connective tissue has two types:
1. white fat - large unilocular cells
2. brown fat - multilocular, heat production
53
afferent neurones carry _____ info ____ the CNS
sensory
towards
54
as the rib articulates with the thoracic vertebrae and sternum, what three things are formed
1. costovertebral (rib + vertebrae)
2. costotransverse (rib + transverse facet of vertebra)
3. sternocostal joints (sternum and rib)

55
bone connective tissue has _________ ECM, which does what
mineralised
supports structures and protects organs
56
can the spinal cord move during flexion and extension of vertebral column?
yes slightly up or down
57
cardiac muscle also contain intercalated disks which are /do what?
specialised junctions
support rapid, co ordinated contraction
58
cardiac muscle function and location
pump blood through heart
found only in myocardium
59
cardiac muscles have ____ _______ fibres with _______ nuclei that is central/peripheral?
shorter, branched
one or two
central
60
cartilage connective tissue in A_________ and S______ __________
avascular
shock absorbing
61
cervical C1 to C7 spinal nerves emerge from the intervertebral foramen _____ their numerical vertebrae
above
62
CNS =
brain and spinal cord
63
connective tissue 4 roles:
structural support
medium for exchange
defence insulation
energy storage
64
connective tissue is composed of 3 things:
cells - secrete and mantain ECM
fibres
ground substance
65
connective tissue proper includes which two types
loose (areolar) connective tissue - more cells, fewer fibres
dense connective tissue - fewer cells, more fibres
65
dermatomes of adjacent spinal nerves actually ____________. whats the clinical significance?
overlap slightly
so cutting of a single spinal nerve will not lead to a easily detetctable sensory loss
66
does cardiac muscle have striations?
sometimes
67
does smooth muscle have striations?
no
68
dorsal and ventral rami contain ______ neurones
both neurones, sensory and motor
69
dorsal and ventral roots converge to form a ____________ and what kind of nerve is it?
spinal nerve
mixed, carrying both motor and sensory info
70
dorsal rami deliver information where?
erector spinae group at posterior of body
71
dorsal root and rootlets are ______- ent fibres
afferent
72
dorsal root ganglia contain cell bodies of _____
sensory neurones
73
each fascicle in a peripheral nerve are surrounded by a sheath of specialised cells which form __ to ___ layers and is callled _______
2 to 7
perineurium
74
each neuron has a _____ cell body with cytoplasmic _____
nucleated
process
75
each ventral ramus forms an __________ nerve which passes ____ into the intercostal space between the two ribs giving branches to the _________
intercostal nerve
anteriorly
intercostal muscles
76
efferent neurones carry _____ info ____ the CNS
motor
away
77
function of pectoral muscles (2)
1. move upper limb (like flexion or adducation of humerus)
2. assist in forced inspiration
78
grey matter is composed of ________________, and its arranged within which two structures?
cell bodies of neurones
1. dorsal (posterior) horn
2. ventral (anterior) horn
79
how come there are 8 cervical spinal nerves but only 7 cervical vertebrae or 7 cervical spinal segments
an 8th cervical spinal nerve emerges below 7th cervical between it and 1st thoracic vertebrae
80
how is the skin also supplied by the intercostal nerve
via lateral cutaneous branch (to ur sides) and an anterior cutaneous branch (anterior chest)
81
how might external and internal obliques flex trunk
contract at same time
82
how might transversus abdominis increase intra abdominal pressure
contract and compress
83
in the peripheral nervous system, what is referred to as a 'nerve fibre'
each axon and its supporting schwann cells
84
in the skin, sensory nerve endings (_______ receptors) detect _____, ________, _______ and ________
where is the info then transmitted
cutaneous
touch, pressure, pain and temperature
back to CNS in spinal nerves or in the head (cranial nerves)
85
individual nerve fibres and blood vessels within a fascicle of a perhipheral nerve is surrounded by _______ which is what
endoneurium
delicate loose connective tissue
86
is cardiac muscle voluntary or involuntary, and what is it regulated by (2)
involuntary
pacemaker + ANS
87
is smooth muscle voluntary or involuntary
involuntary (ANS)
88
line of pull meaning, and what 3 movements do line of pull + attachment muscles result in
direction in which a muscle exerts force when it contracts
flexion, extension, rotation
89
most human relfexes involve one or more ___________
interneurons
90
motor info is transmitted from ___ to ________ cardiac muscle, glands etc via _____
CNS
involuntary
ANS
91
motor info is transmitted from ___ to ________ skeletal muscle via _____
CNS
voluntary skeletal muscle
Somatic nervous system
92
moving a limb away from midline (e.g spine) is ____, bringing it back is ____
abduction
adduction
92
muscle fibres are aligned in directions which indicate ___________
- so vertically orientated _______, and oblique fibres (diagonal) enable _______ + ______
direction of pull
pull body up/down
twisting and lateral movements
93
nerves consist of collections of :
axons and/or dendrites situated outside CNS
93
once sensory axons have entered spinal cord (from dorsal root ganglia), what two things may they do?
1. synapse w motor neurone whos axon leaves spinal cord at same segmental level
2. sensory info transmitted upwards (thru diff segment lvls) via ascending pathways to integrating centres in brain
- motor info then transmitted via descending pathways to spinal cord to emerge in ventral roots
94
pectoralis major. what direction are the fibres? and what is it connectd to?
horizontal
humerus
94
pectoralis minor. what direction are the fibres? and what is it connectd to?
superolaterally
scapula
95
pelvic gidle comprises the _____ bone, which articulate at the ______
hip
sacrum (lower back sort of dip)
96
peripheral nerves can be divided into two:
cranial nerves - carry info to and from brain
spinal nerves - carry info to and from spinal cord
97
PNS =
nervous structure outside CNS, connecting CNS to body
98
ribs articulate w thoracic vertebrae ________(anterior/posterior), and articulate with the sterum via costal cartilages _______ (anterior/posterior)
posterior
anterior
99
sensory neurones are located in the dorsal ______ ______
root ganglia
100
skeletal muscle function and location
1. produces voluntary movement of body and limbs
2. attached to bones via tendons
101
skeletal muscle have ____ _________ fibres with _____ __________ nuclei
long cylindrical
multiple pheriphal nuclei
102
skeletal muscle in cross section views, fibres appear in groups.
each fibre is surrounded by _________
the bundle of fibres (______) surrounded by _______
whole muscle surrounded by ________
endomysium
fasicle, perimysium
epimysium
103
smooth muscle are ______ shaped cells, with a _______ nuclei that is perpheral/central?
spindle
single central
104
smooth muscle function and location
moves contents through hollow organs
e.g gut, blood vessels, digestive tract, airways etc
105
spinal cord extends from lower border of the _____ _____ in the skull to the lvl of the intervertebral disc between the _____ vertebrae
foraemn magnum
L1/L2
106
synovial joints are ______ moveable, cartilaginous joints are _______ moveable, and are often found in _______ of the body
freely
slightly, midline
107
the bones in the skeleton can be split into two skeletons. which two? and what do they include?
axial: head, neck, trunk
appendicular: pectoral and pelvic girdles, limbs(arms and legs)
108
the dorsal and ventral roots are formed by a number of .....
dorsal and ventral rootlets
109
the groups of fascicles in a peripheral nerve are bound together by _______ which is what
epineurium
dense irregular connective tissue
110
the lowest of the intercostal nerves continue into the _________, to supply what?
abdomen
abdominal wall muscles and overlying skin
111
the mjority of spinal nerves emerge from _______ which immediately divide into a small __________ and a larger __________
intervertebral foramen
dorsal ramus
ventral ramus
112
the pattern of distribution of spinal nerves is c_______ (___________)
consistent (dermatomes)
113
the skeleton is....
the assemby of bones which give the body its from (shape)
114
the spinous processes in the thoracic region are _____ and point _____ whereas cervical and lumbar spinous processes point _____
long and inferior
horizontal
115
there are __ pairs of cranial nerves, and they emerge from the ____ and leave the skull through the ______
12
brain
many foramina
116
thoracic cage includes (3)
costal cartilages
12 pairs of ribs
sternum
117
thoracic, lumbar and sacracl spinal nerves emerge from the intervertebral foramen _____ their numerical vertebrae
below
118
two types of bone connective tissue
compact - dense
spongy - lighter
119
ventral rami deliver information where?
intercostal muscles (anterior)
120
ventral root and rootlets are ______- ent fibres
efferent
121
vertebral column is made up of ___ vertebrae organised into __ regions. what are all the regions called and how many do they contain?
33, 5
cervical (7) - supports head
thoracic (12) - connects to ribs
lumbar (5) supports lower back
sacral (5) part of pelvis
coccygeal (4) tailbone
122
what 3 bones form the axial skeleton
skull
vertebral
thoracic cage
123
what are 5 functions of the skeleton
rigid supporting framework
protection of soft tissues e.g skull, or vertebral column protecting spinal cord
faciliatation of movement
resistance to action of gravity
surface of attachment for muscles
124
what are antagonists muscle
oppose main action or modulate movement to mantain control
125
what are between the articular facets(vertebral joint surfaces), and what do they do
small facet joints
work tg to balance flexibility with protection of spinal cord

126
what are in between vertebrae, and they are _____ moveable
intervertebral discs (secondary and cartilaginous joints)
slightly

127
what are synergists
groups of muscles acting in synergy
- produce smooth, coordinated motion to generate main force for movement
128
what are the 3 mechanic style principles by which movement is achieved?
bones = levers
joints = fulcrums
muscle contraction provides the force to move/pull on bones across synovial joints
129
what are the 3 types of cartilage connective tissue
1. hyaline - smooth joint surfaces
2. elastic - flexible
3. fibrocartilage - durable
130
what are the common cells present in connective tissue
fibroblasts (active, secrete ECM) and fibrocytes (less active, involved in healing)
131
what are the cytoplasmic processes which recieve information from other neurones called
dendrites
132
what are the two types of dense connective tissue, and whats the arrangement of fibres
- dense regular - fibres regular arranged to resist forces unidirectionally e.g tendons
- dense irregular - fibres irregularly arranged to resist forces in various directions
133
what can the pectoralis major help humerus do?
primarily adducts, medially rotates, horizontally adducts humerus at shoulder joints
134
what can the pectoralis minor help humerus do?
doesnt directly attach to humerus, but pulls scapula affecting limb
134
what direction of fibres do internal and external intercostal muscles take, and what role does it help em play
external - inferiomedially --> elevate ribs, aid in inspiration
internal - superomedially --> depress ribs and aid in forced expiration
135
what do deep muscles in the back do?
extension and lateral flexion of vertebral column
important in mantaining upright posture
136
what do deep stabilisers do
stabilise or support joints
- active in even subtle postural adjustments
137
what do nerve plexuses allow
multiple nerve fibres (e.g spinal nerves arising from several spinal cord segment lvls)
to be distributed in a single pheriperal nerve
138
what does a peripheral nerve consist of
bundle/many bundles (fascicles) of nerve fibres
139
what does ECM determine
properties of connective tissue type
140
what does flexion and extension do, and which plane does it ocur in
flexion - dec angle between bones
extension - inc angle
saggital
141
what does the ground substance in connective tissue contain and what does it allow
a gel like material rich in complex carbohydrates and glycoproteins
- allows for fluid diffusiion, cushioning, and cell adhesion
142
what does the pectoral girdle connect, and what does it include
arms to body
it includes the clavicles (collarbone) and scapulae (shoulder blades)
143
what fibres are contained within connective tissue and what do they do (3)
1. collagen (strength)
2. elastin (flexibility)
3. reticular fibres (supportive meshwork)
144
what four types of specialised connective tissue are there
1. cartilage
2. bone
3. adipose tissue
4. blood
145
what good quality do all DENSE connective tissue have
high tensile strength
146
what is an example of lateral flexion
leaning side to side
147
what is dermatome
area of skin supplied by a single spinal nerve/spinal cord segment
148
what is included in the Anterolateral abdominal wall (4)
external oblique
internal oblique
transversus abdominis
rectus abdominis
148
what is loose connective tissue good for, and what does it lack
molecular/cellular diffusion
lacks tensile strength
149
what is myotome
a group of skeletal muscles innervated by a single spinal nerve/ spinal cord segment
150
what is the function of the anterolateral abdominal wall
1. flexion and rotation of trunk
2. compression of abdominal contents
3. stabilisation of spine
151
what is the role of muscles (3)
produce movement at synovial joints
stabilise body position (posture)
generate heat
152
what is the simplest form of a neural pathway which activates a reflex
somatic reflex arc
153
what is the single cytoplasmic process that c onducts impulses away from cell body called
axon
153
what is the skeletal muscles striated appearance due to
regular arrangement of contractile proteins actin and myosin
154
what is this

costal cartilage
155
what makes up the extracellular matrix ECM
fibres and ground substance
156
what muscles are included in intercostal muscles (3)
external, internal and innermost intercostal
157
what nerves deliver to skeletal muscle
somatic
158
what skeleton (out of the two) does the vertebral column belong to, and what is it comprised of (3)
axial
vertebrae, fused sacrum and coccyx (tailbone)
159
what two categories come under ALL connective tissue
1. connective tisssue proper
2. specialised connective tissue
160
what two muscles make up pectoral muscles, and where are they at
pectorialis major and pectoralis minor
anterior to shoulder joint
161
what type of info is trasnmitted at dorsal horn
sensory
162
what type of info is trasnmitted at ventral horn?
motor
163
whats the function of intercostal muscles
support ribcage and assist in breathing by controlling movement of ribs
164
where are deep muscles in back and what do they include
run longitudinally along the back, lateral to spinous processes
erector spinae group
165
where do bones articulate with each other
joints
166
where is the anterolateral abdominal wall, and what is the orientation (of fibres) of each muscle
intercostal space between two adjacent ribs
1. external runs inferomedially (hands in pocket, towards the midline but running down)
2. internal runs superomedially (towards the midline, but running up)
3. transversus abdominis - horizontally
4. rectus abdominis - vertically
167
which groups are used to extend the spine, and how can u produce a lateral flexion
quadratus lomborum muscle + erector
1. contracts unilaterally, so one side contracts
2.quadratus lumborum muscle pulls trunk towards that side
3. erector laterally flexes trunk when acting unilaterally
168
which specific joints allow facilitation of movement
synovial joints
169
white matter has a white colour due to ______
myelinated axons withhin the longitudinal fibres
170
why in adult life, does spinal cord end at the lvl of intervertebral disc L1/L2 (conus medullaris)?
becasue the vertebral column grows faster than spinal cord
171
why is vagus nerve, which is the cranial nerve X (10) an exception to how cranial nerves usually behave?
it innervates structuresin thorax and abdomen, not head and neck


